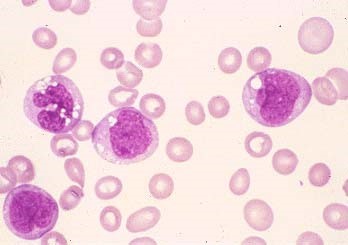

Follicular lymphoma molecular
T(14;18) bcl2-IgH
Primary cutaneous follicle center lymphoma (PCFCL) vs nodal follicular lymphoma
Most cases PCFCL lack t(14;18) are Bcl6 pos, but Bcl2 and CD10 neg Vs in lymph node FL has t(14;18) and is pos for BCL6, BCL2 and CD10
APL flow
CD33+/CD177+/CD34-/HLA-DR-
immunophenotype CLL/SLL
B-cell markers: CD19, CD20 (*dim), CD22
CD5+ CD23+
Neg for CD10 Bcl6- FMC-7
*CD38 pos and ZAP-70+=bad prognosis
Immunophenotype mantle cell lymphoma
B-cell markers: CD19, CD20 (bright), CD22, FMC-7
CD5+ CD23- Cyclin D1+ CD43+
CD10/Bcl6- Bcl2+
Immunophenotype of follicular lymphoma
CD10+ Bcl6+ Bcl2+ (90%)
CD5- CD23-
t(14;18): IgH-Bcl2
Immunophenotype of marginal zone lymphoma
B-cell markers; nothing specific
Which two lymphomas express CD25
Hairy cell leukemia (also CD20, CD22, TRAP)
Adult T cell leukemia/lymphoma
What lymphoma shows T-cell rosettes?
NLP hodgkin lymphoma CD3+ CD57+ T cells surround LP cells forming rosettes
Burkitt lymphoma translocation
t(8;14) MYC-IGH
Which 3 lymphomas express CD30?
What distinguishes plasmablastic lymphoma from other plasma cell neoplasms?
EBER+
Flow findings in PNH
Which BCR-ABL isoform is associated with CML?
p210 isoform of t(9;22) BCR-ABL
Which BCR-ABL isoform is associated with B-ALL?
p190 isofrom of t(9;22) BCR-ABL
What subtype of AML is associated with thrombocytosis and giant agranular platelets?
AML with inv3
Translocation in acute monocytic leukemia
t(8;16) blasts with characteristic cytoplasmic vacuoles
Blasts w/ characteristic vacuoles
acute monocytic leukemia t(8;16)
Diagnosis?

toxoplasmosis
Favorable prognostic factors B-ALL
hyperdiploidy
t(12;21) TEL1-AML
Poor prognostic factors B-ALL
Hypodiploidy
t(9;22) BCR-ABL
del17p
t(11q23) MLL rearrangement
What B-cell neoplasm shows clumpy “soccer ball” chromatin on peripheral smear and cytology?
CLL/SLL
What translocation is found in mantle cell lymphoma
t(11;14) CCND1-IgH
results in cyclin D1 amplification
FISH is best assay
Diagnosis?

Marginal zone lymphoma
“monocytoid” lymps w/ abundant clear cytoplasm